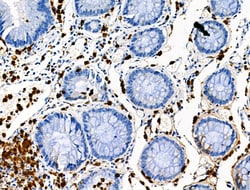
Invitrogen Phospho-CEACAM1 (Ser508) Polyclonal Antibody 100 &mu;L | Buy Online | Invitrogen&trade; | Fisher Scientific

missing translation for 'onlineSavingsMsg'
Learn More
Learn More
Invitrogen™ Phospho-CEACAM1 (Ser508) Polyclonal Antibody


Description
Antibody detects endogenous levels of CD66/CEACAM1 only when phosphorylated at Ser508.
CEACAM1 is a member of the carcinoembryonic antigen (CEA) gene family, which belongs to the immunoglobulin superfamily. Two subgroups of the CEA family, the CEA cell adhesion molecules and the pregnancy-specific glycoproteins, are located within a 1.2 Mb cluster on the long arm of chromosome 19. Eleven pseudogenes of the CEA cell adhesion molecule subgroup are also found in the cluster. The encoded protein was originally described in bile ducts of liver as biliary glycoprotein. Subsequently, it was found to be a cell-cell adhesion molecule detected on leukocytes, epithelia, and endothelia. The encoded protein mediates cell adhesion via homophilic as well as heterophilic binding to other proteins of the subgroup. Multiple cellular activities have been attributed to the encoded protein, including roles in the differentiation and arrangement of tissue three-dimensional structure, angiogenesis, apoptosis, tumor suppression, metastasis, and the modulation of innate and adaptive immune responses. Multiple transcript variants encoding different isoforms have been reported, but the full-length nature of only two has been determined.

Specifications
Specifications
| Antigen | Phospho-CEACAM1 (Ser508) |
| Applications | Immunohistochemistry (Paraffin), Western Blot |
| Classification | Polyclonal |
| Concentration | 1 mg/mL |
| Conjugate | Unconjugated |
| Formulation | PBS with 50% glycerol and 0.02% sodium azide; pH 7.4 |
| Gene | CEACAM1 |
| Gene Accession No. | P13688, P16573 |
| Gene Alias | antigen CD66; ATP-dependent taurocolate-carrier protein; bb-1; BGP; BGP1; BGP-1; BGPI; BGPR; Biliary glycoprotein 1; biliary glycoprotein D; bone gamma-carboxyglutamic acid (Gla) protein; carcinoembryonic antigen 1; carcinoembryonic antigen 7; carcinoembryonic antigen related cell adhesion molecule 1; carcinoembryonic antigen-related cell adhesion molecule 1; carcinoembryonic antigen-related cell adhesion molecule 1 (biliary glycoprotein); Cc1; C-CAM; C-CAM 105; Ccam1; CD66a; CD66a antigen; Cea1; Cea-1; Cea7; Cea-7; CEACAM1; CEA-related cell adhesion molecule 1; CEA-related cell adhesion molecule 1 (bone gamma-carboxyglutamic acid (Gla) protein) (osteocalcin); Cell-CAM 105; ecto-ATPase; GP110; hepatitis virus (MHV-4) susceptibility; hepatitis virus receptor; Hv2; Hv-2; mCEA1; Mhv-1; MHVR; MHV-R; MHVR1; mmCGM1; mmCGM1a; mmCGM2; murine hepatitis virus receptor; osteocalcin; pp120; pp120/ecto-ATPase |
| Gene Symbols | CEACAM1 |
| Show More |
Product Title
By clicking Submit, you acknowledge that you may be contacted by Fisher Scientific in regards to the feedback you have provided in this form. We will not share your information for any other purposes. All contact information provided shall also be maintained in accordance with our Privacy Policy.
Spot an opportunity for improvement?